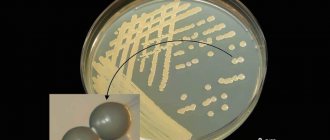

General concepts
At the beginning of the progression of the disease, the clinical manifestations of pneumonia can be easily confused with the clinical manifestations of bronchitis. Only an experienced doctor can correctly differentiate these two diseases. If he can make a correct diagnosis in a short time, then a certain therapy will be prescribed very quickly, which gives a much greater chance of a successful prognosis.
Among the similar symptoms of pneumonia and bronchitis are the following:
- difficult breathing;
- heat and fever;
- signs of general poisoning of the body;
- lack of oxygen;
- long and persistent cough mixed with pus.
And yet, the following clinical manifestations will help the doctor establish the correct diagnosis in adults:
- shortness of breath, which is a clear symptom of pathology;
- attacks of unproductive cough with complicated mucus discharge;
- pain and discomfort in the chest area;
- high temperature, indicating an inflammatory process;
- poor general condition.
In addition, in order to confirm the correct diagnosis, the doctor must take images to assess the condition of the bronchopulmonary system. For this purpose, certain clinical tests are prescribed.
Causes of pneumonia
The cause of any pneumonia is infection. Most often, the causative agent of the disease is bacteria: pneumococcus, Haemophilus influenzae, pathogenic staphylococci and streptococci. During an influenza epidemic, viral pneumonia, characterized by a lightning-fast course, comes to the fore. In people with severely reduced immunity, fungal pneumonia or pneumonia caused by protozoa, such as mycoplasma, is possible. In approximately 30% of cases, pneumonia is of a mixed nature, that is, caused by a complex of several bacteria or an association of viral and bacterial agents [4].
But in addition to the infection itself, predisposing factors are important. Increases the risk of diseases:
- Acute respiratory viral infection . The most common infection is influenza.
- Prolonged hypothermia. It causes microcirculation disorders and inhibits the functioning of the ciliated epithelium, which cleanses the bronchi from pathogenic microorganisms.
- Stress, hypovitaminosis and overwork.
- Smoking.
In addition, the likelihood of developing pneumonia increases in older people and people with underlying chronic diseases, as well as obesity. Such pneumonia can be primary viral (develop after the flu) or secondary bacterial - when pathogenic bacteria penetrate into a weakened body (see Table 1).
Table 1. Differences in the main types of pneumonia
Sign
Viral pneumonia
Bacterial pneumonia
Start
Acute: within the next 24–72 hours after the first flu symptoms appear
2 weeks after first symptoms
Manifestations of intoxication
Temperature above 38°C, headache, muscle pain from the very beginning of the disease
After the first wave of symptoms caused by the virus, relief occurs, then the temperature rises sharply again, a headache occurs, and the cough intensifies
Clinical symptoms
From the first hours - a painful dry cough, sputum streaked with blood, chest pain, shortness of breath
First, the condition stabilizes, then a second wave of symptoms begins: the cough becomes even more intense, purulent sputum appears
How can pneumonia be treated?
Pneumonia is a deadly disease. Therefore, under no circumstances should you engage in diagnosis and treatment based on advice from the Internet: at the slightest suspicion of pneumonia, you should call a doctor. If the doctor insists on hospitalization, you should not risk refusing it. Pneumonia is dangerous due to disruption of vital organs due to severe intoxication, as well as respiratory failure. In such a situation, even emergency artificial ventilation may be required.
When talking about drugs for the treatment of pneumonia, the first thing that comes to mind is antibiotics . Indeed, they are indispensable if pneumonia is of a bacterial nature. In this case, drugs based on a combination of amoxicillin and clavulanic acid are most often prescribed. If they are ineffective, use cephalosporins, macrolides or so-called respiratory quinolones.
The effectiveness of antibiotic therapy is assessed 48–72 hours after prescription. If during this period the temperature decreases, the intensity of the cough and the severity of intoxication (headache, weakness, aches in muscles and joints) decrease, the course of treatment is continued. If the patient's condition does not improve, the drug is changed to a drug from another group.
The recommended course of antibiotics must be completed to the end, without stopping treatment even if the dynamics are positive. Otherwise, there is a high risk of developing antibiotic resistance and relapse of the disease.
For viral (influenza) pneumonia, antibiotics are ineffective and therefore are not prescribed. In this situation, antiviral agents such as oseltamivir and zanamivir are recommended. In addition to them, the doctor may prescribe umifenovir as part of complex therapy. The earlier they are prescribed, the higher the effectiveness of antiviral drugs. Ideally, 48–76 hours should pass from the first symptoms to the start of antiviral treatment.
If the doctor suspects the mixed nature of pneumonia, he may prescribe both antibacterial and antiviral agents.
Immunomodulators (immunoglobulins) and vitamins may be recommended as adjuvant therapy .
Physiotherapy for pneumonia is prescribed only after the temperature has normalized in order to speed up the removal of phlegm from the lungs. For this purpose, herbal remedies are often taken, for example, licorice root or complex breast mixtures.
Prevention of pneumonia
Until now, vaccination remains the most effective method of preventing pneumonia. There are vaccines against the most typical pathogen, pneumococcus, and influenza vaccines that prevent the development of viral pneumonia.
How to recognize the onset of an illness
Many experts are still confident that therapy for this disease is possible only by taking penicillin antibiotics. Modern pathogenic microorganisms have learned to develop resistance to these drugs.
Pneumonia is treated with broad-spectrum antibiotics. In the first days of therapy in a hospital, the doctor prescribes these drugs to the patient. As a rule, this must be done before the sick person is correctly diagnosed and the true source of the disease becomes known.
Before prescribing a specific pharmaceutical product, the doctor must make sure that the patient does not have allergic reactions to a particular drug product.
Modern medicine actively uses antibiotic drugs of the second and third generations to treat inflammatory pathologies.
If viruses are to blame, then antibacterial therapeutic tactics will not be appropriate. It will be necessary to add antiviral agents to the general treatment regimen.
How many days does it take to treat pneumonia - what affects recovery time - Stop Colds
Pneumonia is one of the most common infectious diseases. It is characterized by an inflammatory process in the lung tissue, most often occurs acutely, and is caused by various groups of pathogenic microorganisms. It is classified according to severity, causative agent, size and localization of the lesion, as well as community- and hospital-acquired.
Etiology of the disease
Pneumonia occurs in different age groups of the population; the average incidence in Russia is 3.9 cases per 1000 people per year. The highest incidence of pneumonia is observed among children under 5-7 years of age and the elderly population (20-45 cases per thousand population).
Infectious agents that cause pneumonia are various viruses, bacteria, fungi, and protozoa. The most typical and common causative agent of pneumonia is the bacterium Streptococcus pneumoniae. Atypical pneumonias include chlamydial, legionella, mycoplasma and viral. The main factors in the development of pneumonia are decreased immunity, both local (respiratory tract) and general.
Factors affecting the rate of healing
- Type of infectious agent.
Pneumonia caused by Enterobacteriaceae, Pseudomonas aeruginosa, Acinetobacter, Legionella and Pneumocystis are characterized by the most persistent and prolonged course of the process and resistance to antibiotics. In addition, any bacterial pneumonia can last a long time if the bacteria have multiple resistance to antibiotics. - State of health, chronic diseases.
Pneumonia takes the longest and most severe course in people with a history of diabetes mellitus, renal failure, or congenital pathology of the immune system. Pneumonia in drug addicts and patients with HIV is characterized by a particularly long and persistent course, severe shortness of breath, and involvement of almost all lung tissue. - Patient's age.
Children under five years of age have features of the cellular composition of the blood - lymphocytes predominate among leukocytes, the immune response to the pathogen is imperfect, in addition, there are anatomical features (weakness of the respiratory muscles, the formation of more viscous bronchial secretions, a small area of lung tissue compared to adults) , these factors lead to the fact that inflammation in childhood occurs more often and is more severe than in adults. Up to a year, viral pneumonia occurs more often; they are characterized by a faster course and the possibility of life-threatening spasm of the respiratory tract. The next increase in incidence is observed in old age. - Complication of a previous viral infection. By multiplying in the epithelium of the respiratory tract, the virus facilitates the establishment of bacteria in them and the development of complications. In this case, the cause may also be the person’s own flora, which is normally present in the respiratory tract and does not cause disease.
- Acute and prolonged stress, hypothermia, exhaustion of the body, malnutrition, overwork.
- Long hospital stay. Many hospital departments have their own nosocomial flora, where bacterial strains are extremely resistant to disinfectants and antibiotics and can survive for a very long time. Such bacteria can cause the development of nosocomial pneumonia in humans, which is characterized by a long course and complex therapy.
- Allergic diseases accompanied by bronchial hyperactivity. This leads to increased secretion formation in the bronchi, narrowing of their lumen, and stagnation of mucus in the lungs, which creates conditions for the proliferation of bacteria.
- Chronic inflammation of the bronchi (smoker's bronchitis, COPD). Constant inflammation of the mucous membrane creates favorable conditions for the proliferation of bacteria.
Classification of disease by infectious agent
Typical pneumonia, main representatives: Streptococcus pneumonia (pneumococcal infection), Haemophilus influenzae, various types of staphylococci. The treatment period for uncomplicated mild forms is 5-7 days, depending on the course of the chosen antibiotic and its effect.
In people with weakened immune systems, pneumonia can be caused by bacteria such as Pseudomonas aeruginosa, Legionella, Staphylococcus aureus, Klebsiella, Chlamydia, and Mycoplasma. The duration of treatment will be from 15-20 days to 1.5 months (for abscess formation), hospitalization in a hospital is required.
People living with HIV are often affected by Pneumocystis pneumonia.
Typical for newborns and children one year of age. They are often a manifestation of congenital intrauterine infection. Typical representatives: adenovirus, CMV and RS infection, influenza viruses, parainfluenza.
The duration of uncomplicated forms is 3-7 days, but very often a viral infection is complicated by the addition of a bacterial one, and the treatment period is extended to 15 days.
Hospitalization in a hospital is advisable; young children often have asthma attacks due to respiratory viral infections.
Differences in the need for hospitalization
- Does not require hospitalization. Up to 75% of all patients belong to this group; they suffer from mild pneumonia and only need outpatient treatment in a clinic.
- Requires hospitalization.
This group includes people with moderate pneumonia, those with severe symptoms of the disease, patients with a mild form but with serious chronic diseases, infants and young children, people with low social status, the elderly after 70 years, patients at risk of aspiration and some others categories of patients. These patients are in the therapeutic or pulmonology department. Treatment time is about 10-21 days, depending on the x-ray dynamics and the type of pathogen. - Category of people requiring hospitalization in the intensive care unit. This includes patients with severe forms of pneumonia, children under one year old, and persons with life-threatening conditions.
Severity of pneumonia
- Mild severity. Body temperature up to 38 C, respiratory rate up to 25 movements per minute. Intoxication is not pronounced, pulse is within normal limits. Symptoms of pneumonia are mild, some of them are absent.
- Moderate severity.
Temperature up to 39 C, shortness of breath up to 30 respiratory movements per minute, increase in heart rate up to 100 per minute.Intoxication is severe, there are headaches, severe weakness, chills, morning and night sweats.
- Severe degree.
A sharp deterioration in the patient's condition, temperature up to 40 C, severe shortness of breath (>30), retraction of the intercostal spaces, possible lag of the diseased half of the lungs in the act of breathing. Accelerated heart rate (>100), severe intoxication, possible loss of consciousness, delirium, development of complications (pleurisy, purulent abscesses, pneumothorax, sepsis, infectious-toxic shock).
Currently (2015), scales are often used to assess the severity of a patient’s condition and prognosis (PSI - prognosis assessment, BTS, ATS, EPO criteria, CURB-65 - assessment of indications for hospitalization and admission to the ICU).
Features of immunity affecting the course of the disease
Our body has a developed and well-functioning immune system that protects us from most foreign agents that constantly come into contact with us. Bacteria and protozoa that cause pneumonia are constantly in the air and in the lungs, but not everyone who comes into contact with them develops the disease.
The largest vulnerable groups are children and the elderly. They have a physiological decrease in immunity.
There are congenital diseases that reduce immunity - primary immunodeficiencies (Bruton's disease, DiGeorge syndrome, various hypogammaglobulinemia). The frequency of these diseases is extremely low, and they all manifest in early childhood.
Secondary immunodeficiencies. This group includes people with HIV. Many of them get sick with atypical forms of pneumonia (mycoplasma, pneumocystis). The treatment of such pneumonia is very long, often patients are in intensive care and the outcome of the disease is unfavorable.
Taking glucocorticoid hormones and cytostatic therapy also causes a pronounced decrease in immunity and increases the risk of bacterial infections.
Socially disadvantaged segments of the population. The incidence among them is higher than the average for the age group. This is explained by poor nutrition, unsatisfactory living conditions, unsanitary conditions, overcrowding, and lack of funds for antibiotics.
What determines the success of treatment
The duration of the disease is affected by:
- patient's age;
- state of immunity, chronic diseases;
- timeliness of seeking medical help;
- correct diagnosis and prescription of rational antibiotic or antiviral therapy.
Drugs of choice for antibiotic therapy
According to the recommendations, treatment for uncomplicated mild forms of community-acquired pneumonia should begin with protected penicillins (amoxicillin/clavulanic acid, amoxiclav).
In case of allergy to penicillins or suspicion of atypical pneumonia, the initial therapy is the prescription of macrolides (azithromycin, clarithromycin). Instead of protected penicillins, it is permissible to prescribe cephalosporins (cefuroxime axetil).
Alternatives include levofloxacin and moxifloxacin.
In cases of mild pneumonia, only oral antibiotics are possible. For moderate pneumonia, parenteral intramuscular administration of antibiotics, followed by transfer to oral administration. For severe pneumonia, antibiotics are prescribed mainly parenterally intravenously. You can read more about the treatment of pneumonia here.
Criteria for the effectiveness of antibiotic therapy
- Reduction in the severity of clinical symptoms (decrease in temperature, disappearance of shortness of breath, weakness, normalization of well-being, reduction in cough intensity).
- Changes in blood picture according to analysis data. Reducing the number of neutrophils, eliminating the shift in leukoformula.
- Reduction of inflammation in the lungs according to radiographs.
Criteria for changing antibiotics
- Lack of clinical effect 48 hours after the start of therapy (general condition, temperature curve, respiratory rate, pulse).
- Obtaining antibiogram data, indicating the sensitivity of bacteria to antibiotics.
- No positive changes on the x-ray, negative x-ray dynamics in the lungs.
Average treatment time
| Community-acquired typical pneumonia | Nosocomial pneumonia | Atypical forms of pneumonia | Pneumonia in immunocompromised individuals | |
| Lightweight | 5-7 days | 7-15 days | 7-14 days | 14-21 days |
| Average | 5-15 days | 10-21 days | 10-21 days | 14-21 days |
| Heavy | 10-21 days | 14-56 days | 14-56 days | 21 days |
Source: https://solsalut.ru/gorlo/skolko-dnej-lechat-vospalenie-legkih-chto-vliyaet-na-sroki-vyzdorovleniya.html
About the duration of treatment in detail
How long does it take to treat pneumonia? This issue worries all patients, because everyone wants to get better quickly and return to their normal lifestyle. Predicting the duration of treatment will depend on what therapeutic tactics will be chosen for a particular person. It can be carried out on an outpatient basis or in a hospital. How long this will last depends on the severity of the pathological process.
The reason for hospitalization can be many different factors. Thus, people who, for some reason, cannot be treated with pharmaceuticals are subject to mandatory hospitalization. Before registering a patient for inpatient treatment, the severity of the pathological process is established. For this purpose, radiography is necessary.
After this procedure is completed, the difference in physiological data is compared: blood pressure, heart rate and respiration. In acute cases, there is an infectious process accompanying the disease. If there is a certain suspicion of the presence of concomitant pathologies of the cardiovascular system and gastrointestinal tract, mandatory treatment in a hospital is carried out. To all these points it is worth adding the presence of tumor formations.
The duration of treatment directly depends on the quality of therapy and the nature of the disease
How long pneumonia is treated depends on the type of disease, the effectiveness and correctness of the chosen medication tactics, as well as the human body’s reaction to prescribed pharmaceuticals. In general, with the general course of the pathology, the duration of time spent within the walls of the hospital will last approximately up to four days. However, in some cases, the attending physician may continue therapy with the patient in order to monitor the condition longer and prescribe more intensive treatment tactics.
How long does it take to treat pneumonia in adults?
“How long does it take to treat pneumonia?”
- Many patients and doctors faced with pneumonia are looking for the answer to this question. Despite the wide range of antibiotics and the latest drugs, the course lasts at least 15 days. The duration depends not only on the technique, but also on the patient’s living conditions, his responsibility and consciousness.
To find out how long it will take to recover from an illness, it is necessary to consider the nature of pneumonia, as well as its symptoms.
Pneumonia: what is it?
Pneumonia is a fairly serious and common disease characterized by damage to the alveoli and inflammation of the lungs. As a rule, the cause of the lesion can be viruses or an infection received from the outside.
The term “pneumonia” unites a whole group of diseases characterized by different etiology, pathogenesis, and clinical picture. Despite the development of medicine, 6% of patients die from this disease every year.
The main cause of mortality is untimely hospitalization and inaccurate diagnosis (especially in underdeveloped countries). It is characteristic that the mortality rate in adults is much lower than in children: this is due to the characteristics of the body and the ability to “fight” the virus.
Today, pneumonia is not fatal, and pneumonia is treated everywhere. To get rid of inflammation, as well as return to a healthy lifestyle, you need to consult your doctor in time.
Only a medical professional will tell you how to get diagnosed and prescribe the necessary course.
Ambulatory treatment
Depending on the severity of the disease, as well as the individual characteristics of the patient’s body, the doctor may decide on “home”, outpatient treatment. According to statistics, about 70% of patients are treated outside the hospital.
If you want to be treated at home, it is important to remember about bed rest, as well as gentle exercise. It is not recommended to leave your home, play sports or go to work. Inflammation cannot be cured “on the legs.”
During outpatient treatment, the patient takes strong antibiotics and is necessarily visited by a doctor. As a rule, improvement occurs after 4–5 days, and inflammation disappears completely after 15–20 days.
The body's defenses
The duration of the disease directly depends on the state of the person’s immune system. People who suffer from any chronic pathologies, as a rule, suffer from the disease somewhat longer than others.
Weakening of the body as a whole may be due to the effects of specific pathologies. Thus, the situation is extremely unfavorable in case of HIV status, as well as conditions with immunodeficiency. Hormonal agents used for therapeutic purposes in autoimmune pathologies have a negative effect on the body.
Features of pneumonia treatment
Pneumonia requires complex treatment. Its duration directly depends on the effectiveness of the prescribed measures. Therapy should include:
- Antibacterial drugs – to combat pathogenic microorganisms.
- Bronchodilators - remove obstacles to the free discharge of sputum.
- Antihistamines - prescribed if there is an allergy to medications.
- Analgesics – eliminate pain.
- Vitamins and mineral complexes support the immune system and stimulate the body's protective functions.
- Oxygen therapy is an effective treatment method that is auxiliary in nature. The blood is artificially oxygenated to avoid the development of anemia and other complications.
- Physiotherapeutic procedures help improve expectoration.
- Bed rest - the patient should be at rest, reclining on the bed, changing body position from time to time. This is done to prevent sputum from stagnating. It is important to ensure a complete balanced diet and plenty of fluids.
If pneumonia is characterized by a chronic type of course with periodic exacerbations, you should be more attentive to your health, without neglecting preventive measures. To do this you can do the following:
- exclude the possibility of body hypothermia;
- maintain the body’s immune reserves with vitamin and mineral complexes, especially in the off-season;
- do not take unnecessary risks by communicating with sick people;
- take medications to prevent infection with respiratory diseases;
- observe the rules of personal hygiene;
- spend more time in the fresh air and ventilate the room.
If you notice a deterioration in your health, you should not delay visiting a specialist, because the sooner a diagnosis is made and adequate treatment is started, the less time it will take to recover. The most important thing is to take full responsibility for your health and not self-medicate.
How is pneumonia diagnosed?
Inflammation in the elderly
For people who have crossed the sixty-year mark, pneumonia is considered a very dangerous illness. The body's defenses in these individuals are greatly weakened by various chronic pathologies. If you ask: how long does it take to treat pneumonia in old people, then the answer will be little different from the duration of treatment in young and middle-aged people.
People in this group should take more careful care of their health. If it so happens that pneumonia has developed, then therapeutic tactics can only be carried out in a hospital setting.
Systematic monitoring, the ability to administer medications through injections and droppers, special nutrition and strict bed rest - all this will help speed up the healing process and prevent the occurrence of sad consequences. So, how long does it take to treat pneumonia in the elderly? This process generally takes about two weeks in a hospital, then therapy is extended at home.
Gymnastics in the treatment of disease
It is worth emphasizing that the timing of treatment for pneumonia will depend not only on the medications prescribed. Therapy should be carried out from the very beginning of the development of the pathological process, and gymnastic exercises will help with this. To begin with, the patient should change positions in bed more often.
There is no need to load the painful side and lie on it. Breathing exercises should be carried out approximately on the third day. You need to inhale gradually, slowly drawing in your abdominal muscles. Repeat this action approximately several times for 15 approaches. Such treatment can also be supplemented with other movements; bending the body is very useful.
Features of care and nutrition
Proper care and nutrition will help the patient get back on his feet faster
If treatment takes place on an outpatient basis, then the patient requires proper care. If there is excessive sweat production, it is necessary to promptly change bed and underwear. To expectorate sputum, the patient must have his own separate spittoon.
The room where the sick person is located should be systematically ventilated and wet cleaning should be done there. A person must have his own hygiene items, as well as eating utensils. If symptoms of complications occur, you should visit your doctor again.
You should eat high-calorie and fortified foods, but at the same time fatty foods are completely excluded from the menu. Drinking a large amount will help increase mucus production and prevent dehydration due to severe intoxication.
A person should drink up to three liters of water per day. An excellent solution would be alkaline water, compotes, and fruit drinks.
Unconventional tactics
Many people practice traditional treatment. This is their choice and their health, however, you should definitely consult a doctor. Some healers recommend taking raisin decoction. To prepare the medicine, you need to grind a handful of raisins in a meat grinder, pour in a glass of boiled water and keep on fire for about ten minutes. Then the medicine must be carefully strained, squeezed out and taken three times a day.
Fig medicine is also quite effective. To prepare it, take two fruits each and add milk, after which they boil for about a quarter of an hour. What you get should be consumed about a glass twice a day. Nuts, consumed in large doses, are good for dry cough.
Home rehabilitation after pneumonia. How to recover faster
What inhalations should you do at home to quickly restore damaged lungs after pneumonia? Do I need to take vitamins and immunomodulators? How to train breathing so that shortness of breath does not develop?
We asked these questions to a pulmonologist with 50 years of experience, Honored Doctor of Belarus, Associate Professor of the Department of General Medical Practice of the Belarusian State Medical University, Ph.D. Irina Lapteva. In the past, Irina Mikhailovna was the head of the clinical department of pulmonology at the Republican Scientific and Practical Center of Pulmonology and Phthisiology, and the chief freelance pulmonologist of the Ministry of Health.
You have extensive work experience. What can you say about coronavirus pneumonia: is it worse than the previous ones?
Doctors all over the world encounter viral pneumonia every year. The main difficulty is that new strains of viruses periodically arise, against which there are no vaccines or medicines when they appear. A pandemic occurs when a new virus spreads throughout the world and most people are not immune. This is exactly the situation that is currently observed with the COVID-19 infection due to its very high infectiousness (contagiousness).
COVID-19 is not as deadly as other coronaviruses. It kills about 4%, mostly people with diseases that cause immunodeficiency and the elderly. Children rarely get sick.
In general, are viral pneumonia more severe than bacterial pneumonia?
There are several options for the manifestation of viral pneumonia. Primary viral pneumonia is the most severe. This is pneumonia in the first two days with lightning-fast development of symptoms and involvement of other organs and systems of the body in the process.
Often there are variants of pneumonia that complicate the course of ARVI, when by the end of the first week ARVI is accompanied by pulmonary symptoms: cough with sputum, chest pain when inhaling, coughing. This is a variant of viral-bacterial pneumonia, in which the virus played the role of a conductor of bacterial infection.
A common variant of pneumonia is when the patient has recovered from acute respiratory viral infection, but in the second week the so-called second wave of infection occurs, usually bacterial, which is manifested by fever and pulmonary symptoms. This is secondary bacterial pneumonia.
The volume of lung damage is of great importance. Therefore, it is very important to start treatment in a timely manner and prevent the progression of the disease.
What are the main complications of viral pneumonia?
Viral pneumonia itself is a complication. Its course, in turn, can be complicated by the appearance and progression of shortness of breath, which can be interpreted as severe acute respiratory syndrome, and the development of failure of other organs, such as the kidneys, liver, and heart. Such multiple organ failure is characteristic primarily of primary viral pneumonia, when the virus enters the blood (viremia). In addition, the so-called hemorrhagic syndrome may develop, which was observed in 2009 with viral pneumonia caused by the swine flu strain.
About breathing exercises and nutrition
What should you do first for rehabilitation after pneumonia?
One of the main goals is to restore lung function and eliminate residual symptoms, such as prolonged cough. Recovery time can range from one to three months. It is important to practice breathing immediately after finishing antibiotics. You need to start with the simplest exercises so that shortness of breath or cough does not develop.
Breathing exercises include the following exercises:
- holding your breath while inhaling (from 10–15 seconds to 1 minute);
- holding your breath while exhaling (from 5–10 seconds to 40 seconds);
- inhale and exhale quickly for a few seconds;
- breathing with maximum stretching of the chest and all intercostal spaces;
- inflating balloons - to develop the intercostal muscles and diaphragm.
The number of times each person determines for himself individually - according to his condition and well-being.
Rehabilitation at home includes physical education. They are necessary after pneumonia: by increasing the mobility of the chest, they prevent the development of adhesions in the pleural cavity. Do what is familiar to you.
It is important to sleep at least 8 hours at night. Before going to bed, you should take a walk in the fresh air. Even now there is no need to be afraid of it. The lungs need air . At any time of the year, you need to ventilate the apartment twice a day. Wet hygienic cleaning is also required.
Alcohol consumption should be avoided. If possible, stop smoking. If you are bothered by a strong cough and are unable to give up a bad habit, it is recommended to reduce the number of cigarettes and smoke less than before the illness. .
You should also avoid hypothermia.
What to change in nutrition and diet?
Proper nutrition is the basis for restoring lung function. During pneumonia, the body spends a lot of energy to overcome the infection. You can restore your strength by consuming enough proteins (meat, fish, legumes). At the same time, it is necessary to limit fried and spicy foods, as these dishes cause stress in the functioning of internal organs, which leads to worse recovery of the respiratory system. You also need to drink plenty of water: mineral waters, herbal teas with thyme, mint, lemon balm - this helps flush out bacterial toxins and tissue breakdown products and speed up the recovery of the lungs.
About probiotics and vitamins
Should I take probiotics and for how long?
When treating pneumonia while taking antibiotics, the intestinal microflora dies. In this case, discomfort in the abdomen, bloating, loss of appetite, nausea, belching, and aversion to a certain type of food may occur. In addition, disruption of the intestinal microflora can have long-term consequences: decreased immunity, allergies to foods that previously did not cause problems, weight gain. In this regard, doctors often recommend a probiotic containing lacto- and bifidobacteria. It is better to take the drug simultaneously with an antibiotic, observing a three-hour interval. And then switch to kefir and yogurt, which contain lactic acid bacteria.
Do I need to take vitamin complexes and adaptogens?
Yes. You can take multivitamins, but not more than one month. The instructions will tell you more about the dosage regimen.
The ability of adaptogens to restore the body's strength under the most extreme conditions is well known. The strongest are considered to be Leuzea, Eleutherococcus, Echinacea and ginseng. Then come lemongrass and aralia. Golden root, pollen, rose hips, and royal jelly are also used. Incorporating herbal adaptogens into the treatment of pneumonia may prevent adverse antibiotic reactions and accelerate clinical improvement. But you need to know that their use has a lot of contraindications and some seasonal restrictions. In the summer, especially in the heat, it is better not to take these drugs at all, since at this time of year they have virtually no therapeutic effect, but can cause headaches and rapid heartbeat. Take adaptogens no more than once a day, preferably in the morning. And the doctor selects the dosage.
Can immunodeficiency occur after pneumonia?
During the inflammatory process in the lungs, the immune system is activated to fight the pathogen. During treatment, immune mechanisms may become depleted, which can lead to a new infection or relapse of the disease. To prevent undesirable consequences, herbal immunomodulators are used: tinctures of Chinese lemongrass, echinacea, and eleutherococcus.
About physiotherapy
Due to the fact that it is not worth visiting clinics now, what physical procedures can be performed at home?
In the first days of the recovery period, it is necessary to continue removing residual sputum (mucus) from the respiratory tract. To do this, you can use alkaline inhalations at home: breathe warm mineral water through an inhaler. Inhalations with drugs that dilate the bronchi are also possible, especially if you feel difficulty breathing (as prescribed by a doctor). If you don’t have an inhaler, you can breathe under a towel with a warm soda solution (40 g of soda per liter of water).
When the borders open, where is the best place to go on vacation after suffering from pneumonia?
A person recovers faster and more effectively in familiar, familiar conditions. Spa treatment is indicated only several months after pneumonia. Rest in a sanatorium is the last stage of rehabilitation. The most favorable resorts for the respiratory system are forested areas.
How to cheer up after severe pneumonia amid a pandemic?
Everything depends on ourselves. It is in our power to adequately and correctly assess the situation: a panicked or sad mood will not contribute to success. Cultivate positive emotions.
Your recommendations for prevention: how to support and strengthen the body and lungs so as not to get sick or easily suffer a new infection?
Necessary:
- Timely vaccination (seasonal flu, pneumonia)
- take vitamin and mineral complexes
- exercise regularly
- eat well
- have a good rest
- observe the rules of hygiene.
Subscribe to our Telegram channel, groups on Facebook , Twitter and stay up to date with the latest news ! Only interesting videos on our YouTube , join us
How to prevent the disease
When an adult takes a course of antibiotic drugs, after which significant changes for the better begin to be observed, an imaginary recovery is often mistakenly established. The patient must adhere unquestioningly to the treatment regimen, even if the temperature has returned to normal and the clinical manifestations have completely disappeared. Only the attending doctor will be able to tell how long it takes for a complete cure.
In no case should you reduce the dosage or change the tactics of using medications.
Eliminating any drugs from use by interrupting the course of therapy would be a grave mistake on the part of the patient. As a result, this action can contribute not only to the emergence of unforeseen consequences, but also become chronic. To recover completely, you must adhere to the strictest instructions for taking pharmaceutical medications and adhere to all medical prescriptions.
To prevent flare-ups after recovery, the body needs:
- walk in the fresh air;
- get rid of all bad habits;
- engage in some type of activity;
- fill your diet with rich fortified foods;
- take vitamins from time to time;
- avoid hypothermia;
- drink herbal teas instead of regular ones.
It is important, when the first complaints appear, to immediately go to a medical institution at your place of residence, where you should undergo a comprehensive examination and a course of appropriate treatment.
Author of the publication: Anna Umerova
Remember! Self-medication can cause irreparable consequences for your health! At the first symptoms of the disease, we recommend immediately contacting a specialist!
Preventive procedures
If a patient takes a course of antibiotics prescribed by a doctor and experiences a noticeable improvement in his health, this does not mean that the person has recovered. It is necessary to continue rehabilitation therapy for some time, even if the patient’s temperature has returned to normal and other symptoms of lung disease have disappeared. The attending physician will tell you how long the disease can be treated after antibiotics.
In no case should the patient independently reduce the dose or change the regimen of drug use.
This is especially true for injections), exclude any drugs from use, abruptly interrupt the treatment process or change its timing. All this can lead not only to complications of the disease, since it may be undertreated, but also result in a chronic or protracted form. For a complete recovery, you must strictly follow the doctor’s instructions and follow all his instructions for as long as necessary. For preventive purposes and to prevent relapses of lung disease after recovery, the former patient is recommended to:
- take walks in the fresh air;
- eliminate bad habits;
- go in for sports or at least do gymnastics in the morning;
- include foods rich in vitamins and nutrients into your diet;
- periodically drink a vitamin complex;
- do not overcool;
- use green or herbal tea instead of regular black tea, etc.
The most important rule for a quick recovery is to immediately consult a doctor after detecting suspicious symptoms.